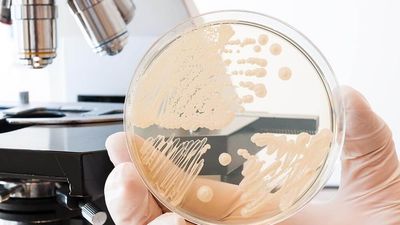
2021/01/Candida-Diet.jpg

Simptomat të cilat tregojnë ekzistencën e candidës në organizëm
Candida është kërpudhë e cila ndihmon te thithja e nutrienëve të ushqyeshëm dhe tretja, por vetëm kur gjendet në nivele të përshtatshme në trup
Kur ndodh prodhimi i tepërt, mund të shfaqen simptoma tipike të candidës.
Candida Albicans është tipi më i shpeshtë i infeksioneve kërpudhore, mund të gjendet edhe në gojë, në sistemin digjestiv dhe në zonën vagjinale.
Gjithashtu, mund të ndikojë në lëkurë dhe në mukozat e tjera, transmeton Telegrafi.
Nëse sistemi i imunitetit funksionon mirë, ky tip infeksioni rrallëherë është serioz. Po, kur imuniteti nuk është i fortë?
Kur ekuilibri natyror i pH-së së organizmit është i çrregulluar, candida mund të rritet jashtë kontrolli në trupin tuaj dhe të krijojë probleme.
Sindroma e rritjes tej mase e candidës është dukuri e cila ka të bëjë me rritjen jashtë kontrollit të candidës në trupin tuaj.
Mos harroni që këtu fjala është për gjendjen kronike shëndetësore.
Personat të cilët kurrë nuk e kanë provuar infeksionin serioz kërpudhor mund të shohin ndryshime në mënyrën tjetër. Përkatësisht, mund të zhvillojnë ndjeshmëri të reja, alergji apo jotolerancë në llojeve të ndryshme të ushqimeve, të cilat më shpesh përfshijnë produkte qumështi, vezë, misër ose gluten.
Ka shumë shkaktarë, duke përfshirë një dietë të pasur me sheqer, karbohidrate të rafinuara dhe alkooli, të cilat ndihmojnë që kërpudhat të rriten. Përveç kësaj, ne veçojmë këto shkaqe të tjera të mundshme:
Antibiotikët
Përdoren për të vrarë bakteret që shkaktojnë sëmundje dhe gjithashtu vrasin edhe florën normale bakteriale mbrojtëse në të gjithë trupin. Shumica janë derivate fungale dhe kjo është arsyeja pse ata funksionojnë kaq mirë. Funksioni i tyre në natyrë është për të lejuar kërpudhave të rritet kështu që ky efekt anësor i tyre ndodh edhe në organizëm ku mundësohet një zhvillim i vrullshëm i tyre.
Përdorimi alkoolit
Alkooli është një produkt i fermentuar dhe për këtë arsye ai nxit rritjen e mykut në organizëm. Përdorimi i rregullt i alkoolit kultivon një kërpudhë të mëlçisë dhe ndryshon neurotransmetusin e trurit duke sjellë varësi ndaj alkoolit.
Përdorimi i rregullt i ushqimeve të fermentuara
Në të njëjtën mënyrë si alkooli nxit rritjen e candidës edhe shumë ushqime të fermentuara si buka, sheqeri , djathi, uthulla e shumë të tjera, nxisin shtimin e sasisë së kërpudhave në organizëm.
Tabletat kontraceptive
Hormonet e kontrollit të shtatzënisë ndryshojnë mënyrën e sekretimit të hormoneve duke siguruar një nivel të qëndrueshëm të tyre e cila pengon vezën e lëshuar nga vezoret për të kryer ciklin e saj natyror. Ky anormalitet i klimës hormonale në trupin e femrës favorizon rritjen fungale e cila tashmë ka terren të lirë për t’u zhvilluar.
Ekspozimi i vazhdueshëm ndaj mykut
Ekspozimi i vazhdueshëm ndaj mykut është një goditje e madhe për sistemin imun dhe gradualisht krijon rritjen e sasisë së mykut në organizëm. Ky problem është i lidhur më së shumti me vendin ku jeton psh: – një shtëpi me lagështirë, kushtet klimaterike (vendet tropikale), afërsia me detin ose oqeanin, profesionet si psh., hidraulikët apo ata që punojnë në ambiente me shumë lagështirë, etj.
Përdorim i kortizonikëve
Kortikosteroidet (kortizonikët) janë medikamente të tilla si prednisoni, hydrocortisoni, dexamethasoni, fluticasoni dhe shumë të tjera në numër. Ata janë përdorur si pilula, inhalues, injeksione, tableta ose kremra për të ndaluar inflamacionin, astmën, alergjinë, skuqjen e lëkurës, dhimbjen e ligamenteve, psoriazën, helmimet, sëmundjet autoimune e shumë të tjera. Këto medikamente shkaktojnë një frenim të aktivitetit autoimun të organizmit dhe në këtë mënyrë mundësohet shtimi dhe popullimi i organizmit nga myku.
Diabeti
Te njerëzit me diabet të tipit 1 dhe të tipit 2, niveli i sheqerit në gojë dhe në mukozat e tjera është më i lartë sesa tek njerëzit që nuk kanë diabet. Meqenëse candida është një lloj kërpudhe dhe sheqeri ushqehet me kërpudha, është e qartë se ata që kanë diabet janë në rrezik më të madh.
Ekspozimi ndaj pesticideve
Ekspozimi në nivele të konsiderueshme ndaj pesticideve dhe agjentë të tjerë që përdoren në bujqësi, kanë sjellë simptomat e candidës për shumë njerëz. Këta agjentë kanë një efekt të ngjashëm me efektin e antibiotikeve në organizëm duke dëmtuar florën e dobishme mikrobiale, prandaj edhe ndikojnë në shtimin e sasisë së mykut në organizëm.
Noti në pishina me klor
Klori është një lëndë kimike që përdoret për të vrarë bakteret dhe algat. Ai nuk arrin që të vrasë mykun që ndodhet me shumicë në pishinë. Meqenëse klori vret edhe florën bakteriale normale të lëkurës sonë, atëherë vendin e saj e zënë myku. Pra, mund të themi se ekspozimi ndaj ujit me klor nuk është aspak diçka natyrale dhe e pranueshme për trupin e njeriut. /Telegrafi/